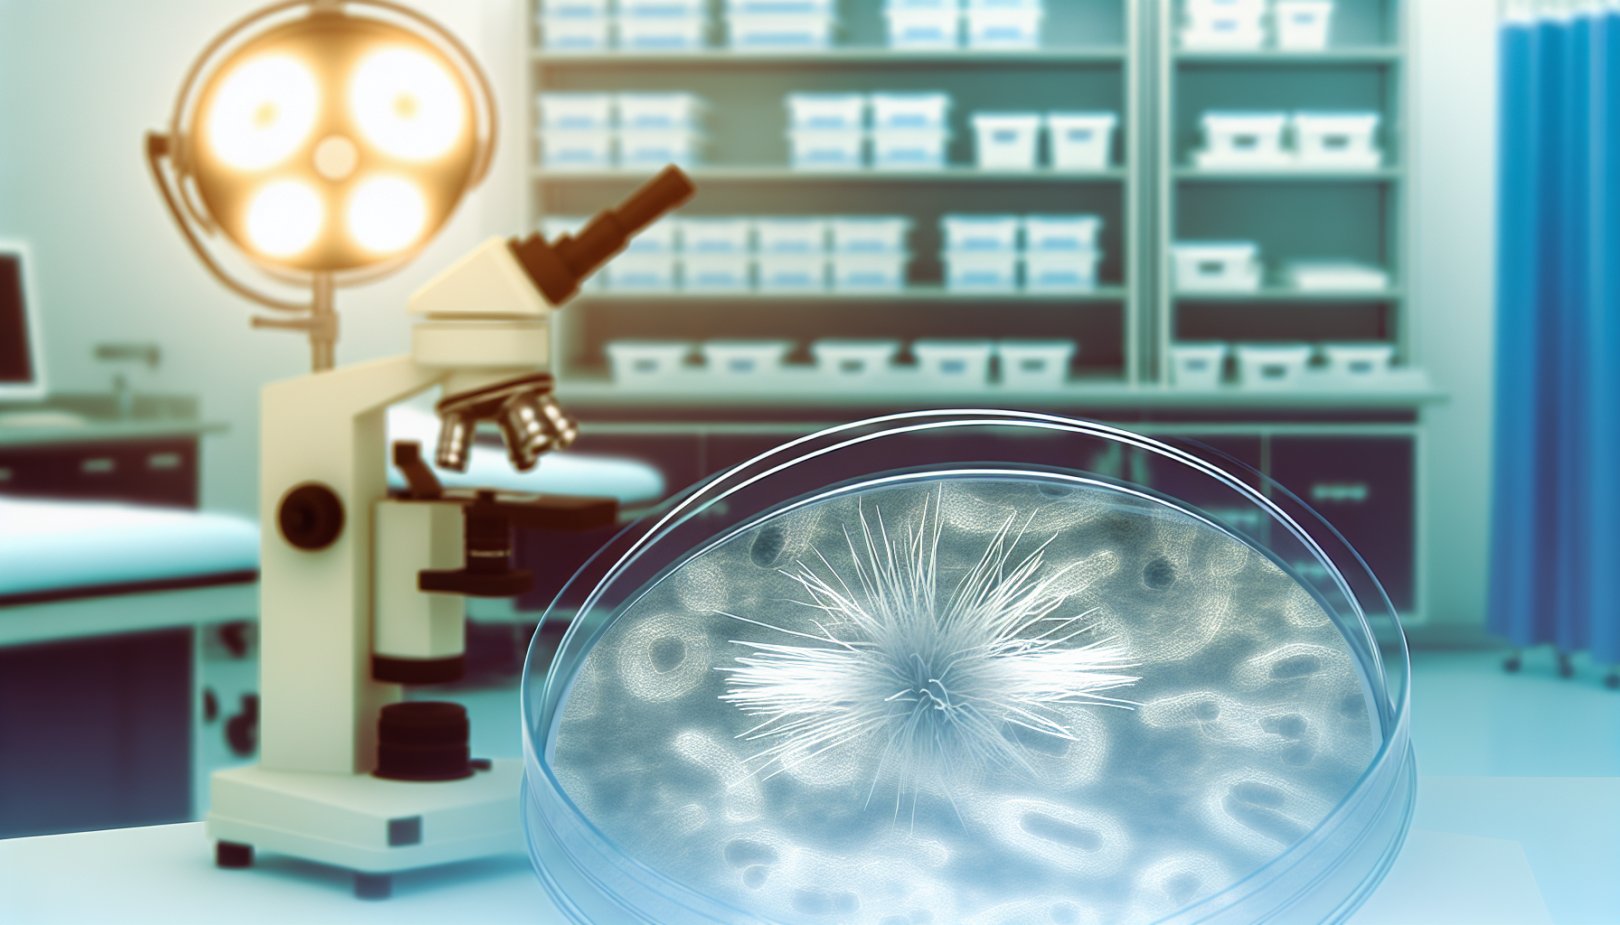

Forskere ved University of Exeter har identifisert en genetisk mekanisme som kan åpne for nye behandlinger mot den dødelige sykehussoppen Candida auris. Soppen har tvunget flere intensivavdelinger til å stenge og motstår alle hovedtyper av soppdrepende medisiner. Funnet gir håp om at eksisterende legemidler kan brukes på nytt.
En farlig sopp med globalt fotfeste
Candida auris er spesielt farlig for kritisk syke pasienter. Den kan leve på huden uten symptomer, men pasienter som er avhengige av respirator løper langt større risiko. Når infeksjon oppstår, dør rundt 45 prosent av pasientene.
Soppen ble først oppdaget i 2008, og opprinnelsen er fortsatt ukjent. Siden den gang er det meldt om utbrudd i over 40 land, inkludert Storbritannia. Den er anerkjent som en alvorlig global helsetrussel og står på Verdens helseorganisasjons liste over kritiske sopppatogener med høyeste prioritet.
Det som gjør situasjonen ekstra alvorlig, er at Candida auris er resistent mot alle hovedtyper av soppdrepende medisiner, noe som gjør behandling ekstremt utfordrende.
Gjennombruddet ved University of Exeter
Det store gjennombruddet kom da forskerne for første gang studerte hvordan gener aktiveres under Candida auris-infeksjon i en levende vert. De brukte en innovativ modell basert på arabisk killifish-larver, en fiskeart hvis egg overlever ved temperaturer som ligner menneskekroppen. Det gjorde det mulig å observere infeksjonen under forhold som nært ligner reell sykdom.
Under forsøkene så forskerne at soppen kan endre form ved å danne langstrakte strukturer kalt filamenter, som kan hjelpe den å søke etter næring mens den infiserer en vert. Samtidig kartla teamet hvilke gener som skrus på eller av under infeksjon for å finne mulige svakheter.
- Flere gener som ble aktive, produserer næringsstoffpumper som fanger jernfangende molekyler og transporterer jern inn i soppcellene.
- Fordi jern er essensielt for overlevelse, kan denne prosessen være en kritisk sårbarhet.
«Siden den dukket opp, har Candida auris skapt kaos der den slår rot i intensivavdelinger på sykehus. Den kan være dødelig for sårbare pasienter, og helseinstitusjoner har brukt millioner på den vanskelige jobben med utryddelse. Vi tror forskningen vår kan ha avslørt en akilleshæl hos dette dødelige patogenet under aktiv infeksjon.»
— Dr. Hugh Gifford, NIHR-klinisk lektor og medforfatter, lege ved Royal Devon & Exeter Hospital
- Oppdaget i 2008; opprinnelse ukjent.
- Utbrudd i over 40 land, inkludert Storbritannia.
- På WHOs liste over kritiske sopppatogener med høyeste prioritet.
- Rundt 45 prosent dødelighet ved infeksjon.
- Resistent mot alle hovedtyper av soppdrepende medisiner.
Nye behandlingsspor – men flere steg gjenstår
Funnene gir håp om at eksisterende medisiner som retter seg mot jernfangingsaktiviteter kan brukes på nytt for å stoppe Candida auris. Samtidig understreker forskerne at det gjenstår flere forskningstrinn før eventuelle behandlinger kan tas i bruk.
Den nye killifish-modellen ble utviklet med støtte fra National Centre for Replacement, Reduction and Refinement (NC3Rs) som et alternativ til bruk av mus og sebrafisk. Studien er publisert i Communications Biology og ble støttet av Wellcome, Medical Research Council (MRC) og NC3Rs.
For å bekrefte at samme genetiske adferd forekommer under infeksjon hos mennesker, trengs det mer forskning. Oppdagelsen av jernfanging som mulig svakhet gir også ledetråder om hvor soppen kan ha sin opprinnelse — muligens i et jernfattig miljø i havet — og peker ut et potensielt mål for både nye og allerede eksisterende medisiner.
Konklusjon: Ved å avsløre hvordan Candida auris utnytter jern under infeksjon, har Exeter-forskerne identifisert en mulig akilleshæl i et av verdens farligste sykehusskadegjørere. Nå blir neste steg å bekrefte funnene i menneskelige infeksjoner og teste om målretting av jernfangst kan gi effektive behandlinger.

Kommentarer
0 kommentarer
Vi godtar kun kommentarer fra registrerte brukere. Dette gjør vi for å opprettholde en trygg og respektfull debatt, samt for å unngå spam og misbruk. Registrering er gratis og tar bare noen sekunder.
Du må være innlogget for å kommentere. Logg inn eller registrer deg for å delta i diskusjonen.